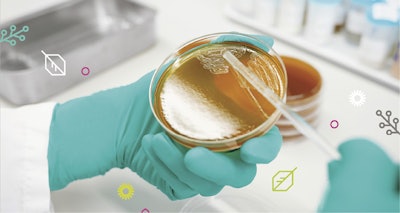
Phc25 043 C&t September Print Advertorial Assets3

The personal care antimicrobials market is experiencing a pivotal transformation. Consumer expectations are evolving rapidly, regulations are becoming more stringent, and regional preferences are more differentiated than ever. Companies operating in this space must do more than deliver antimicrobial efficacy—they must ensure their products are sustainable, multifunctional, and safe.
Ashland is responding to this shift with a forward-looking strategy that integrates sustainability, localized innovation, superior performance and scientific excellence. This approach allows Ashland to meet changing market demands and lead the industry in defining the future of cosmetic preservation.
Responding to a new market reality
Modern consumers are increasingly focused on environmental responsibility, transparency, and wellness. This shift is impacting purchasing decisions and driving demand for products that are both high-performing and aligned with broader values. In the antimicrobial segment, this means moving towards high-performing, sustainable, skin-friendly solutions.
Ashland is actively innovating in this space. The development of bio-based and nature-identical antimicrobial ingredients is helping formulators create safer, more environmentally conscious products without compromising performance. These next-generation ingredients are multifunctional—they not only protect formulations from microbial contamination but also contribute to skin health and sensory appeal.
Safety as a core principle
At the heart of preservation is consumer safety. Products that are not adequately preserved can pose serious health risks and damage brand trust. Ashland’s antimicrobial solutions are developed under rigorous quality standards and are compliant with global regulations. This ensures that they are not only effective, but also gentle on the skin, reducing the risk of irritation or allergic reactions.
Safety also plays a critical role in brand reputation. Consumers are increasingly scrutinizing ingredient labels and are quick to reject products with perceived risks. Ashland helps its customers stay ahead of these concerns by offering preservation systems that are both safe and effective, delivering peace of mind to both formulators and consumers.
Multifunctional ingredients driving innovation
Today’s formulators are seeking ways to streamline product development while still delivering added value. Multifunctional ingredients address this need by performing more than one role within a formulation. A prime example is Ashland sensiva™ sc 50 natural multifunctional, an ingredient that offers gentle antimicrobial protection along with deodorizing, skin-conditioning, and sensory-enhancing properties.
By reducing the number of individual ingredients required, multifunctional antimicrobials simplify formulation processes and support the development of cleaner, more minimalist product labels. This approach is not only efficient but also meets consumer preferences for transparency and simplicity.
Ashland innovations solve customer aspirations

ln 2024 ASH celebrated the company’s 100-year anniversary, recognizing the massive transformation since 1924.
Execute, globalize, innovate and invest
“Ashland is laser future-focused on a strategy to execute, globalize, innovate, and invest to create meaningful change in profitability for the company and provide large organic growth opportunities for customers,” said Guillermo Novo, chair and chief executive officer, Ashland.
To solve the most complex challenges and provide opportunities for step-change growth, Ashland introduced seven exciting new technology platforms aligned to the company’s core that extend to secondary markets with new and differentiated capabilities to unlock organic growth. Ashland’s platform solutions are patented and bring superior performance and “new to the world,” sustainable innovations, offering choice to customers and consumers in personal care, pharmaceuticals, and coatings applications.
“These technology platforms enable customers to reshape global megatrends and respond to various regulatory landscapes,” said Osama Musa, senior vice president and chief technology officer, Ashland. “We are certain of the platforms’ ability to provide tremendous growth opportunities, so we’re asking customers and prospects to challenge us with their wildest aspirations, and we will answer with superior innovations through our joint collaborations.”
Innovate
Many of the company’s new innovations are customized to the specific needs of local communities, and often Ashland is sustainably sourcing local ingredients, putting the power of its people and products in the hands of the communities in which it operates.
Regional differences driving local solutions
One-size-fits-all solutions are no longer viable in today’s global market. Consumer priorities and regulatory environments differ significantly across regions. In Europe, there is a strong emphasis on naturality and ingredient transparency. Asian markets prioritize skin sensitivity and advanced skin care regimens, while North American consumers often look for multifunctionality and value.
Ashland recognizes that success in this complex landscape requires regional agility. Its localized approach to product development ensures that solutions are adapted to meet the specific needs of each market. This enables Ashland to respond more quickly and effectively to customer demands, regulatory changes, and emerging trends.
Asia as a global innovation leader
Among global markets, Asia stands out for its rapid growth and high levels of innovation. Asian consumers are highly engaged with beauty and personal care products, and the region is often the first to adopt new concepts and technologies. This makes Asia a critical driver of global trends in cosmetic preservation.
Ashland has strategically strengthened its R&D presence in Asia to take advantage of this dynamic environment. By collaborating closely with local customers and understanding market-specific needs, Ashland can co-create breakthrough solutions that suit adaptation for global applications. This customer-centric innovation model ensures relevance and speed in a fast-moving industry.
Globalization as a strategic imperative

Ashland’s ability to think globally and act locally is a key differentiator in the marketplace. The company has made significant investments in regional application centers and technical teams in Hamburg, Shanghai, Mumbai, Sao Paulo, and Bridgewater among others. These facilities are staffed with local experts who understand the unique challenges and expectations of their markets.
Regional teams work cross-functionally across technical service, sales, and marketing to deliver integrated, customer-focused solutions. Whether it’s developing a natural preservative system for a shampoo in Brazil or optimizing a facial cream for sensitive skin in Korea, Ashland’s teams are equipped to execute quickly and effectively.
In addition to formulation expertise, Ashland’s localized approach includes strong regulatory capabilities. Regulations governing preservatives can vary widely—from the European Union’s strict ingredient restrictions to evolving frameworks in China and the United States. Ashland’s regional regulatory experts ensure customers receive accurate, up-to-date guidance, helping them stay compliant and reducing the risk of costly reformulations or market delays.
Building a sustainable global supply chain
In parallel with R&D and regulatory investments, Ashland is also expanding its global production footprint. Regional manufacturing facilities are being developed to reduce reliance on long-distance logistics, improve product availability, and minimize the environmental impact of transportation. This initiative supports Ashland’s broader commitment to sustainability by improving supply chain resilience, lowering CO2 emissions, and increasing cost efficiency.
Shaping the future through expertise and innovation

Innovation is the engine driving Ashland’s organic growth and its contribution to the future of the personal care industry. The company’s R&D strategy is structured around:
- New to the world innovation by investing in high-impact research and new molecule development, often in collaboration with academic institutions, to redefine antimicrobial science.
- Broad spectrum blends through designing synergistic combinations of antimicrobial ingredients to deliver effective protection across diverse pH ranges and microbial threats.
- Backwards integration by strengthening control over sourcing and production of raw materials to ensure quality, traceability, and sustainability.
- An unparalleled global network of Technical Service experts helping our customers choose what is best for their formulations. With their expertise in microbiological quality management (MQM), they ensure the high quality of cosmetic products while taking ecological and economic factors into account. Our expert team helps to:
– ensure product and consumer safety
– improve hygiene standards and raw material quality, and
– minimize risks and errors throughout the entire production lifecycle.

Recent innovations demonstrate these principles in action. Ashland phyteq™ raspberry n multifunctional is a naturally derived ingredient that offers antioxidant protection and skin-calming effects along with antimicrobial efficacy—ideal for clean-label, minimalist formulations. Similarly, sensiva™ sc 50 natural multifunctional represents the next evolution in multifunctional antimicrobials, delivering gentle, effective performance with natural origin credentials and a pleasant sensory profile.
Co-creation and customer-centric innovation
Ashland’s global network of technical and application labs allows for both platform-level innovation and customer-specific customization. This flexibility is critical in a world where personalization, speed to market, and differentiation are key to competitive success. Ashland partners closely with customers to co-develop solutions that are not only innovative but also tailored to local markets, brand positioning, and regulatory environments. Additionally, Ashland collaborates strongly with Central Research and Development laboratories in Bridgewater, Zwijndrecht, and Wilmington, and closely with manufacturing teams as an example in Calvert City, KY and Freetown, MA in the United States, among others.
Delivering sustainable, regional, and scientific leadership
As the personal care industry enters a new era defined by responsible beauty, Ashland is leading the transformation of antimicrobial preservation. Through sustainable innovation, regional relevance, and scientific excellence, Ashland continues to be a trusted partner to personal care brands around the world.
With a firm commitment to consumer safety, environmental responsibility, and localized execution, Ashland is shaping the future—one region, one innovation, one consumer at a time.

Disclaimer:
The above paid-for content was produced by and posted on behalf of the Sponsor. Content provided is generated solely by the Sponsor or its affiliates, and it is the Sponsor’s responsibility for the accuracy, completeness and validity of all information included. Skin Inc. takes steps to ensure that you will not confuse sponsored content with content produced by Skin Inc. and governed by its editorial policy.










